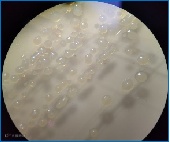

点击蓝字,关注我们
水产养殖芽孢怎么选?一篇文章教会你!
随着养户们养殖意识的不断提高,芽孢在水产养殖领域的应用也是越来越广泛,但是市面上芽孢种类太过杂乱,养殖户们没法判断哪些芽孢产品更适用、性价比更高。其实分辨好的芽孢产品,参考以下标准就可以了。
现在市面上到处都是千亿芽孢甚至是万亿芽孢,大部分养殖户可能觉得标的总菌数越高越好,其实这样的观念是错误的,真正起作用的只有活菌。因此,我们在选择芽孢产品时需要关注的是活菌数量的保证值有多少。
很多养殖户都会问,到底是枯草芽孢好还是地衣芽孢好?其实各类芽孢杆菌所发挥的作用均有所不同,无法单独定义哪种芽孢更好。目前最好的方案就是多种芽孢复合起作用,通过科学合理的配比,让多种芽孢杆菌同时发挥作用,起到综合调理水质的效果。
菌种的环境适应能力是许多养殖户在选择产品时非常容易忽略的一点。很多养殖户用了芽孢之后发现没效果,其实是因为选择的芽孢产品环境适应能力差,比如说所选的产品不耐低温、不耐高盐等,导致用下去的菌没法发挥出效果。
产酶能力简单来讲就是芽孢分解能力的强弱,而由于水体中有机质并不是单一的,因此好的芽孢产品应当具备较强的综合产酶能力。
酶益多

芽孢在水产养殖过程中几乎是不可缺少的动保产品。为了让养殖户在选择芽孢产品时更省心,江门市渔乐生物技术有限公司推出的复合加酶芽孢产品酶益多,挑选多种耐低温、耐高盐度芽孢杆菌,经过科学合理配比,额外添加多种分解酶,保障活菌数≥1.5×1010CFU/g,一包产品帮助养殖户解决多种水体问题。让客户更省心,让养殖更轻松。

推荐指数





产品效果
1、分解动物排泄物、残存饵料、浮游动植物残体等有机残留。
案例展示:冬棚虾塘分解死藻、有机物等
使用前后对比
2、净化有害物质,降氨氮亚盐。
案例:冬棚虾塘降低水体氨氮、亚盐。
向左滑动查看更多
3、抑制有害菌群的繁殖,保障水产养殖动物的健康度。
案例:冬棚虾塘提高虾活力,预防病害。
用量用法
1、产品无需活化,用水稀释后,全塘均匀泼洒使用;
2、养殖前期、低温阶段或清瘦水池塘,建议使用剂量6-8亩·米/袋;
3、养殖中后期、高温阶段,建议使用计量8-10亩·米/袋;
4、可根据池塘实际情况酌情增减用量,建议每月使用2-3次,以保持水质稳定
注意事项:使用本品后开启增氧机;不能与消毒剂、抗生素或杀虫剂同时使用。
渔嘉科技 让养殖更轻松